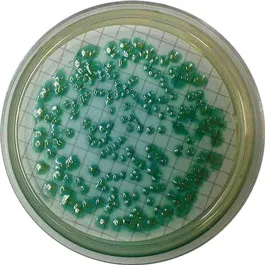

Cetrimide Agar (Eur. Pharm.)
01-160
AOAC / EP / ISO / HP / USP
Solid culture medium for selective isolation of Pseudomonas aeruginosa according to Harmonised Pharmacopoeia Method and 22717 standard.
This medium needs glycerol (Art. No.:GL00261000).
Synonyms: Pseudosel, Pseudomonas Selective Medium, Pseudomonas Selective Agar Base, MEDIUM N EUR. PHARM. 5TH ED.
AOAC / EP / ISO / HP / USP
Solid culture medium for selective isolation of Pseudomonas aeruginosa according to Harmonised Pharmacopoeia Method and 22717 standard.
This medium needs glycerol (Art. No.:GL00261000).
Synonyms: Pseudosel, Pseudomonas Selective Medium, Pseudomonas Selective Agar Base, MEDIUM N EUR. PHARM. 5TH ED.

01-160
AOAC / EP / ISO / HP / USP
Solid culture medium for selective isolation of Pseudomonas aeruginosa according to Harmonised Pharmacopoeia Method and 22717 standard.
This medium needs glycerol (Art. No.:GL00261000).
Synonyms: Pseudosel, Pseudomonas Selective Medium, Pseudomonas Selective Agar Base, MEDIUM N EUR. PHARM. 5TH ED.
Features
+See More
+See More

 Rest of the World
Rest of the World











